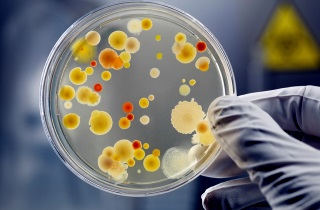
Возникновение пансинусита провоцируется инфекционными возбудителями Причины пансинусита

Формы пансинусита
По мнению специалистов, в настоящее время выделяют несколько типов данного заболевания.
Врачи отмечают, что острый пансинусит является серьезным заболеванием, требующим внимательного подхода к диагностике и лечению. Основные симптомы включают сильную головную боль, заложенность носа, выделения из носа, а также общую слабость и повышение температуры. Специалисты подчеркивают важность своевременного обращения к врачу, так как игнорирование симптомов может привести к осложнениям. Лечение обычно включает антибиотики, если есть бактериальная инфекция, а также противовоспалительные препараты для облегчения состояния. В некоторых случаях может потребоваться хирургическое вмешательство для дренажа синусов. Врачи рекомендуют также использовать промывания носа солевыми растворами и ингаляции для улучшения состояния пациента.

Катаральный пансинусит
Это состояние, при котором наблюдаются покраснение и отек слизистой оболочки. Начинается активное выделение прозрачного секрета (слизи), однако гной не образуется.
| Симптом | Тяжесть симптома | Возможные методы лечения |
|---|---|---|
| Заложенность носа | От легкой до сильной, может затруднять дыхание | Сосудосуживающие капли/спреи (кратковременно), промывание носа солевым раствором, кортикостероидные спреи для носа |
| Гнойные выделения из носа | От скудных до обильных, могут быть желто-зеленого цвета | Антибиотики (при бактериальной инфекции), промывание носа |
| Боль в лице, особенно в области лба, щек и глазниц | От легкой до сильной, может усиливаться при наклоне головы | Анальгетики (парацетамол, ибупрофен), местные обезболивающие средства |
| Головная боль | От легкой до сильной, может быть пульсирующей | Анальгетики, отдых |
| Лихорадка | От субфебрильной до высокой температуры | Жаропонижающие средства (парацетамол, ибупрофен), обильное питье |
| Утомляемость | От легкой до выраженной | Отдых, достаточный сон |
| Нарушение обоняния и вкуса | От незначительного до полного отсутствия | Лечение основного заболевания, в некоторых случаях может восстановиться самостоятельно |
| Отек лица | Может быть незначительным или выраженным | Лечение основного заболевания, в тяжелых случаях – госпитализация |
Экссудативная форма
Эта форма заболевания также характеризуется образованием слизистого секрета в носовых пазухах, что происходит из-за инфекционного поражения эпителиальных клеток.
Острый пансинусит — это воспаление всех синусов, которое может вызывать значительный дискомфорт. Люди часто описывают симптомы как сильную головную боль, заложенность носа, обильные выделения и общую слабость. Многие отмечают, что боль может усиливаться при наклонах головы или в горизонтальном положении. Лечение обычно включает антибиотики, если заболевание вызвано бактериальной инфекцией, а также противовоспалительные препараты для облегчения симптомов. Некоторые пациенты прибегают к ингаляциям и промываниям носа, что помогает улучшить дыхание. Важно не игнорировать симптомы и обратиться к врачу, чтобы избежать осложнений.

Полипозный пансинусит
Это еще одна форма заболевания, возникающая из-за хронического воспаления и отека слизистой (хронический пансинусит). При переходе острого процесса в хронический на поверхности слизистой появляются локальные утолщения, которые со временем могут перерасти в полипы и грануляции.
Гнойный пансинусит
Гнойный пансинусит возникает из-за нарушения связи между носовыми пазухами и носовой полостью. Отек слизистой приводит к блокировке каналов, что вызывает накопление значительного количества слизи. Это создает благоприятные условия для размножения патогенных микроорганизмов, и с увеличением их количества появляется гной.
Гиперпластический пансинусит
Гиперпластический пансинусит отличается длительным течением. В процессе развития этого заболевания слизистая оболочка утолщается, а в пазухах происходит разрастание соединительных тканей. Это негативно сказывается на функционировании слизистых желез и приводит к их дисфункции.
Проявления болезни
Пансинусит: симптомы и проявления
Пансинусит — это заболевание, симптомы которого могут проявляться в различных формах и вызывать значительный дискомфорт. Его проявления объясняются наличием обширного инфекционного очага, который приводит к активному выделению токсинов. Основные признаки пансинусита включают:
-
Общая слабость и повышение температуры — наиболее заметные симптомы, причиняющие пациенту значительное неудобство. Лихорадка возникает из-за отравления организма продуктами жизнедеятельности бактерий. Эти проявления могут варьироваться в зависимости от конкретного случая, формы и тяжести заболевания.
-
Сильная головная боль — еще один характерный симптом. У пациента возникает ощущение давления и повышенного внутричерепного давления. Чувствуется тяжесть в области околоносовых пазух, а анальгетики не приносят облегчения.
-
Заложенность носа — как причина, так и следствие болезни. Это указывает на распространение инфекции из пазух в носовую полость. Отек слизистой оболочки приводит к сужению носовых проходов и может быть вызван закупоркой дыхательных путей гнойными выделениями.
-
Изменение голоса — важный симптом пансинусита. Носовые пазухи перестают функционировать должным образом, и дыхание через нос затрудняется, что приводит к появлению гнусавости.
-
Отечность мягких тканей лица. При пальпации лба, боковых областей носа и зон под глазами могут возникать болезненные ощущения.
-
Субфебрильная температура — в некоторых случаях температура тела может повышаться до 37-38 градусов.
-
Гнойные выделения из носа желтого и зеленого цвета.
-
Быстрая утомляемость — пациенты быстро устают даже после незначительных физических нагрузок и ощущают общую слабость.
Причины появления недуга
Перед началом лечения пансинусита важно выяснить факторы, способствующие его возникновению. Основным из них является инфекция. При остром пансинусите наблюдается активное размножение патогенной монофлоры. Хроническая форма заболевания связана с наличием нескольких микроорганизмов. Чаще всего инфекционными агентами, вызывающими это заболевание, являются:
- стафилококки;
- стрептококки;
- анаэробные бактерии;
- кишечная палочка;
- синегнойная палочка;
- коринебактерии.
Микробы могут попасть в пазухи через воздух при дыхании, через кровь (гематогенное заражение) или через естественные каналы организма. Пансинусит часто развивается на фоне заболеваний верхних дыхательных путей, таких как корь, ринит, грипп и другие. К факторам, способствующим его появлению, относятся:
- курение;
- вдыхание загрязненного воздуха;
- наркомания;
- злоупотребление алкоголем;
- пародонтоз;
- кариес;
- сахарный диабет;
- гормональная терапия;
- химиотерапия.
Дети также могут страдать от этого заболевания, однако у них оно чаще всего связано с аденоидами (патологическими изменениями носоглоточных миндалин). Из-за недостаточной развитости придаточных носовых пазух симптомы болезни могут быть менее выраженными, что затрудняет выявление субъективных признаков пансинусита у детей.
Медикаментозное лечение
Для эффективного лечения данного заболевания врачи назначают курс медикаментов. В первую очередь, это системные антибиотики с широким спектром действия. Чаще всего используются препараты из групп макролидов и цефалоспоринов, такие как «Азитромицин», «Цефтриаксон», «Эритромицин» и другие. Дозировка и продолжительность лечения зависят от формы и степени тяжести пансинусита.
Дополнительно к основной терапии применяются сосудосуживающие капли, которые временно устраняют заложенность носа и способствуют выведению гноя. Наиболее популярными средствами в этой категории являются «Риназолин», «Нафтизин», «Виброцил». Их использование не должно превышать 7 дней, чтобы избежать привыкания.
Промывание носовой полости специальными растворами также показало свою эффективность. Эти процедуры рекомендуется начинать сразу после снятия заложенности и восстановления нормального дыхания. Для промывания применяются солевые растворы и препараты на основе фурацилина.
Наилучший вариант – проводить промывание в стационаре. В экстренных случаях эту процедуру можно выполнять и в домашних условиях, но только при строгом соблюдении всех инструкций.
В дополнение к основному лечению назначаются местные комплексные препараты. Такая терапия начинается сразу после очистки и промывания носовых ходов. Часто используются гомеопатические средства в виде капель, такие как «Афлубин», «Эуфорбиум», «Ларинол» и другие.
Аллергический пансинусит лечится антигистаминами. Эти препараты уменьшают воспаление слизистой и снижают негативное воздействие медикаментов. Наиболее эффективными из них являются «Эриус» и «Лоратадин».
Кортикостероидные препараты показаны при острых формах заболевания. К ним относятся гормональные средства, такие как «Преднизолон» и «Гидрокортизон».
Народная медицина
Пансинусит и народные средства лечения
Пансинусит — серьезное заболевание, требующее обоснованного применения народных средств. Перед использованием рецептов народной медицины обязательно проконсультируйтесь с врачом. Неправильное лечение может ухудшить состояние и навредить здоровью. Какие народные методы могут помочь в борьбе с этой болезнью?
- Промывание носа. Используйте специальные отварные травы, такие как каланхоэ, малина, календула, зверобой и шалфей. Одну столовую ложку выбранной травы залейте литром кипятка и настаивайте 40 минут. Затем слегка теплый отвар заливайте в ноздри и высмаркивайтесь.
- Ингаляции. Этот метод также эффективен при пансинусите. Проводите процедуру над паровой баней с добавлением эвкалипта, ромашки, шалфея и душицы. Однако ингаляции противопоказаны при заболеваниях сердца и легких.
- Прогревания. Они помогают снизить воспаление слизистой. Используйте обычную соль или песок, нагретые на сковороде и помещенные в герметичный мешочек. Прикладывайте его к мягким тканям лица в области носовых пазух. Прогревания не рекомендуются при гнойных и полипозных формах пансинусита.
- Мази и тампонада. Возьмите ватно-марлевые турунды, пропитайте их соком каланхоэ, медом и алоэ. Поместите тампоны в носовые проходы на максимум 20 минут. Это поможет облегчить заложенность носа и уменьшить воспаление.
В качестве более радикального метода может быть применена пункция. Эта процедура актуальна, если медикаментозная терапия оказалась неэффективной. Прокол одной из стенок носовой пазухи позволяет быстро удалить гной и защитить пациента от возможных осложнений.
Полезные советы и профилактика
Основная цель профилактики заболеваний — укрепление иммунной системы. Это позволяет организму эффективно справляться с вирусными инфекциями. Рекомендуем заниматься закаливанием, ежедневно выполнять дыхательные упражнения и поддерживать физическую активность. Улучшение кровообращения и повышение уровня кислорода способствуют быстрому уничтожению вирусов иммунными клетками.
Следуйте простым рекомендациям:
- избегайте чрезмерной сухости воздуха в помещении (оптимально не ниже 50%);
- при пансинусите отложите занятия плаванием в бассейне или море до полного выздоровления;
- пейте больше жидкости (это помогает разжижать слизь);
- придерживайтесь правильного и регулярного питания;
- ведите активный образ жизни;
- откажитесь от вредных привычек (курение, алкоголь);
- замените чай и кофе на отвар шиповника.
Обращайте внимание на сигналы своего организма. При первых симптомах пансинусита незамедлительно обращайтесь к врачу. Не занимайтесь самолечением. Симптомы этого заболевания могут быть обманчивыми и легко спутаться с обычной простудой или насморком. Если у вас болит голова и длительное время сохраняется заложенность носа, не откладывайте визит к врачу.

Вопрос-ответ
Как понять, что у тебя пансинусит?
Пансинусит можно заподозрить по таким симптомам, как сильная боль и давление в области лица, особенно в лобной и гайморовых пазухах, затрудненное дыхание через нос, обильные выделения из носа, а также общая слабость и повышение температуры. Если эти симптомы сохраняются более недели или усиливаются, рекомендуется обратиться к врачу для диагностики и лечения.
Какое лучшее лечение пансинусита?
Иногда для лечения воспаления назначают пероральные, инъекционные или назальные стероиды. Если причиной пансинусита является аллергия, врач может порекомендовать аллергенспецифическую иммунотерапию (аллергенсодержащие инъекции) для улучшения состояния. При наличии полипов или заложенности носа иногда может быть показана хирургическая операция.
Как долго проходит пансинусит?
Острый пансинусит развивается быстро, имеет яркие симптомы и обычно проходит за 4 недели. Если воспаление сохраняется свыше 12 недель, можно говорить о развитии хронического пансинусита.
Советы
СОВЕТ №1
Обратите внимание на симптомы. Острый пансинусит может проявляться сильной головной болью, заложенностью носа, выделениями из носа, повышенной температурой и общим недомоганием. Если вы заметили у себя эти признаки, не откладывайте визит к врачу.
СОВЕТ №2
Не занимайтесь самолечением. При первых симптомах пансинусита важно обратиться к специалисту для получения точного диагноза и назначения адекватного лечения. Использование антибиотиков или других препаратов без назначения врача может усугубить ситуацию.
СОВЕТ №3
Следите за увлажнением воздуха в помещении. Сухой воздух может усугубить симптомы пансинусита. Используйте увлажнители или просто ставьте емкости с водой в комнате, чтобы облегчить дыхание и уменьшить дискомфорт.
СОВЕТ №4
Обратите внимание на режим питья. Употребление достаточного количества жидкости помогает разжижать слизь и способствует её выведению. Пейте воду, травяные чаи и бульоны, чтобы поддерживать водный баланс и облегчить симптомы.